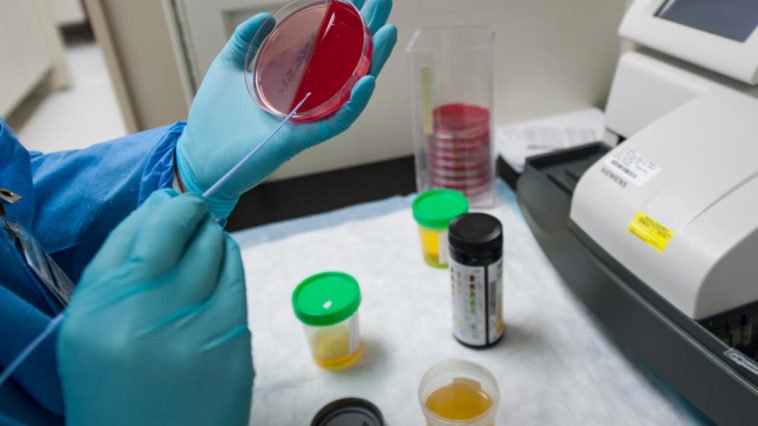
Colore della pipì in test di laboratorio medici esami delle urine

pipì
Più recenti
8 Condivisioni1.3k Views
in SaluteQuante volte al giorno è normale urinare?
30 Condivisioni553 Views
in SaluteCosa dice il colore della pipì sullo stato di salute?
Altre domande
41 Condivisioni501 Views
in Animali, Salute, Usi e costumiCome curare una puntura di medusa?
Sarà capitato un po’ a tutti, di essere punti da una medusa mentre si fa il bagno. È certamente un fastidio, ma nella maggioranza dei casi il tutto si risolve in un paio d’ore. Quindi, cosa bisogna fare se si viene punti? Intanto bisogna uscire dall’acqua senza farsi prendere dal panico, dopodiché sciacquare la zona […] More
33 Condivisioni5.9k Views3 Commenti
in SaluteA cosa è dovuto il brivido della pipì?
No, non sei l’unica persona a cui capita, ma è una sensazione molto diffusa, soprattutto tra gli uomini! Il motivo per cui accade risiede nel fatto che l’urina è molto calda e, quando lascia il nostro corpo, provoca un calo della temperatura corporea. I nostro organismo allora provvederà a riscaldarsi e ripristinare l’equilibrio termico attraverso […] More